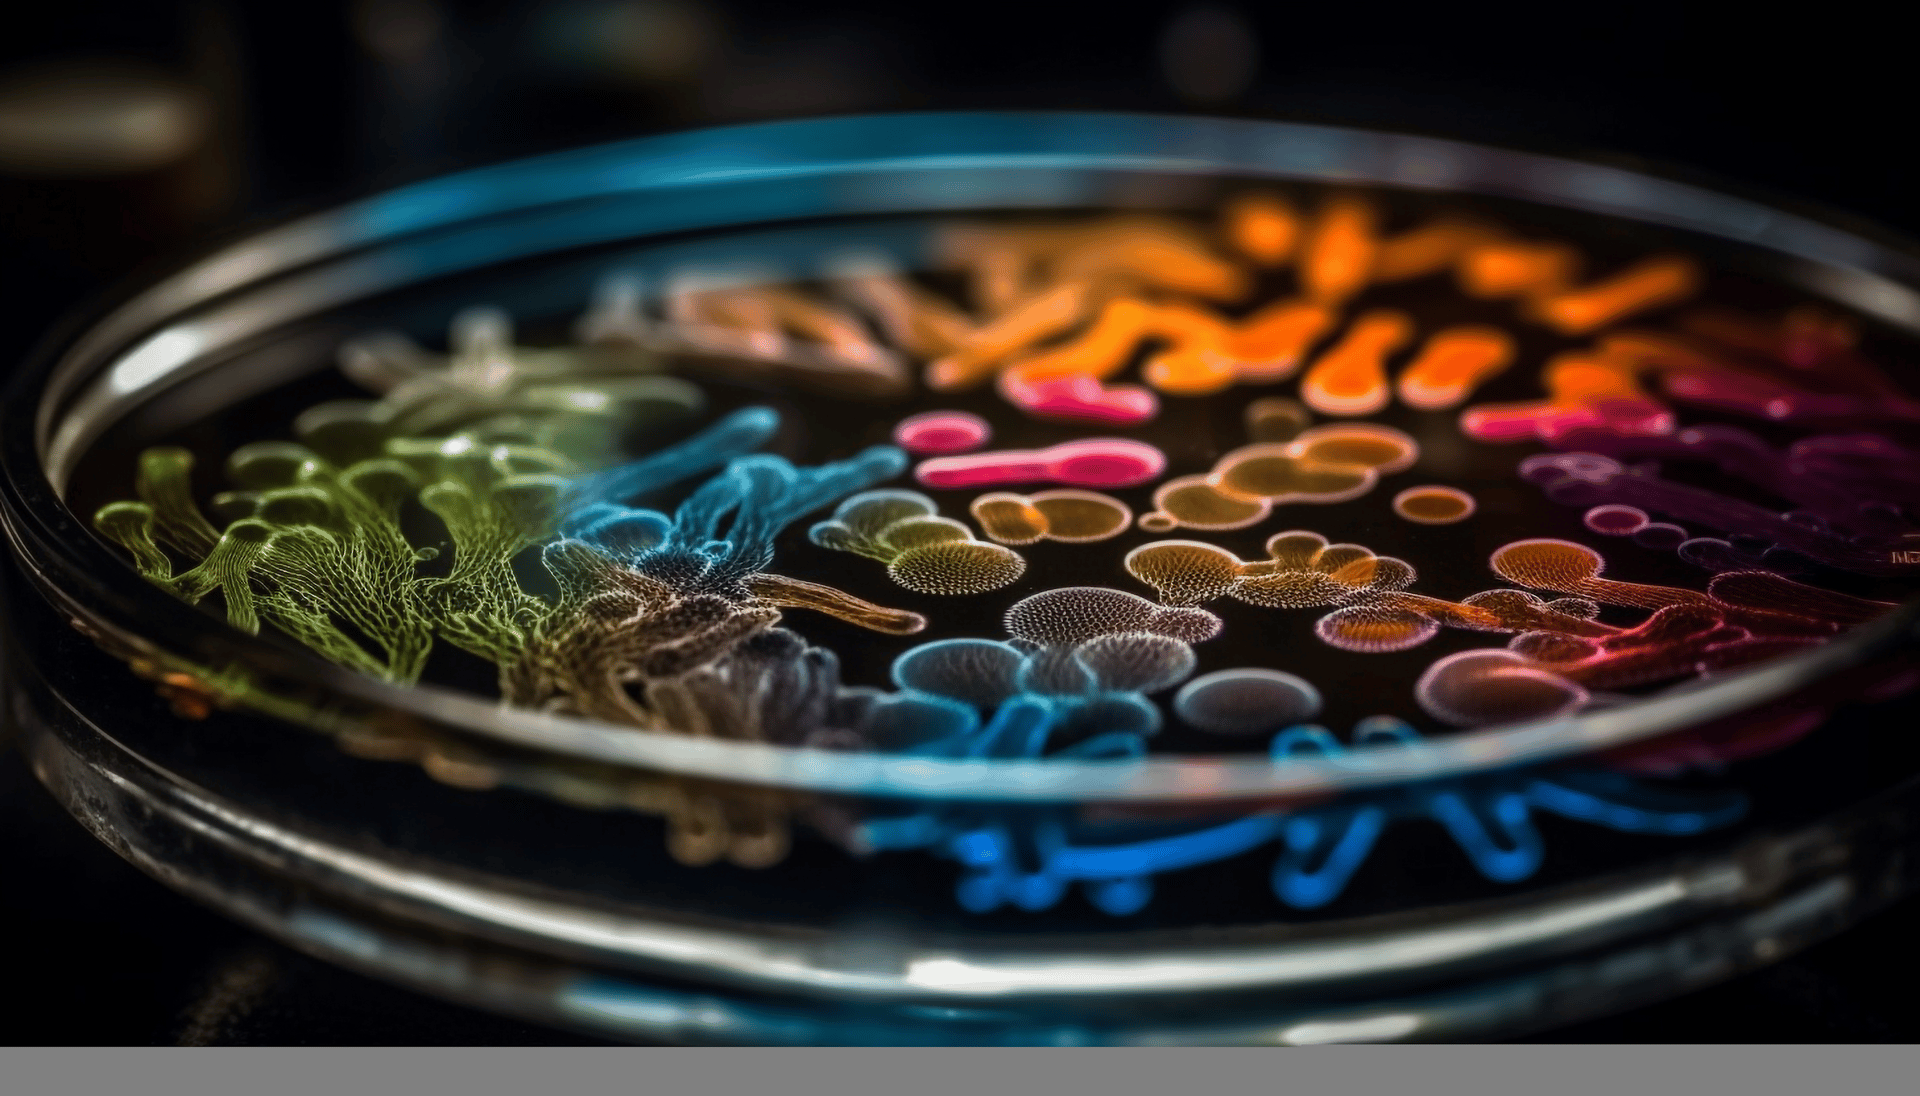

Illuminating Wound Care: The Impact of MolecuLight i:X on Bacterial Detection
Discover how the MolecuLight i:X handheld imaging device transforms wound care by enabling real-time bacterial detection, improving clinical decision-making, and enhancing healing outcomes.
Rafael Wong, Founder/CEO of eleven11co Consulting & Development and eleven11biologics
3/25/2025
Illuminating Wound Care:
The MolecuLight i:X Device
Written by Rafael Wong, Founder/CEO of eleven11co - Consulting & Development | eleven11biologics - Advanced Tissue Products
Follow Rafael at Medium.com/@rafaeleven11co
Building upon our exploration of advanced wound care technologies, this article delves into the MolecuLight i:X, a pioneering handheld imaging device that enhances clinicians’ ability to assess and manage wounds by visualizing bacterial presence in real-time.
Visualizing Bacterial Presence
Traditional methods of detecting bacterial load in wounds often rely on subjective assessments and delayed culture results. The MolecuLight i:X addresses these challenges by utilizing fluorescence imaging to detect bacteria, providing immediate insights into wound bioburden.
This real-time visualization aids clinicians in identifying areas requiring intervention, potentially accelerating healing processes and improving patient outcomes.
A 2022 randomized controlled trial published in Diabetes Care found that the use of autofluorescence imaging (via MolecuLight i:X) increased the rate of diabetic foot ulcer healing at 12 weeks compared to standard care alone (45% vs. 22%) and influenced clinical decision-making, most often resulting in additional wound debridement (Rahma et al., 2022).
Enhance Clinical Decision-Making
The integration of MolecuLight i:X into clinical workflows offers several advantages:
Immediate Feedback: Real-time visualization of bacterial presence
Targeted Treatments: Supports precision care and reduces overuse of antibiotics
Improved Documentation: Enables consistent wound monitoring and outcome tracking
Another large-scale study found that fluorescence imaging improved detection of high bacterial loads fourfold over standard clinical assessments (Le et al., 2021).
Implications for Healthcare Professionals
For frontline staff and mid-level management, adopting MolecuLight i:X offers practical and strategic benefits:
Training & Education: Supports staff development in high-tech wound care tools
Best Practices: Facilitates evidence-based, standardized wound management
Leadership Insight: Equips managers with data to optimize outcomes and resources
Conclusion
The MolecuLight i:X exemplifies the integration of innovation at the point of care. It offers a tangible solution to the longstanding challenges of wound assessment, particularly in complex chronic wounds. At eleven11co, we support healthcare providers and biotech innovators in leveraging such technologies to improve outcomes, streamline care delivery, and advance best practices.
-R
References
1. Rahma S, Woods J, Brown S, Nixon J, Russell D. The Use of Point-of-Care Bacterial Autofluorescence Imaging in the Management of Diabetic Foot Ulcers: A Pilot Randomized Controlled Trial. Diabetes Care. 2022;45:1601–1609.
2. Le L, Baer M, Briggs P, et al. Diagnostic accuracy of point-of-care fluorescence imaging for detecting bacterial burden in wounds. Adv Wound Care. 2021;10:123–136.

Redefining the way WE think through INTEGRATION and COLLABORATIVE EXPERTISE.
eleven11co © 2022. All rights reserved.


